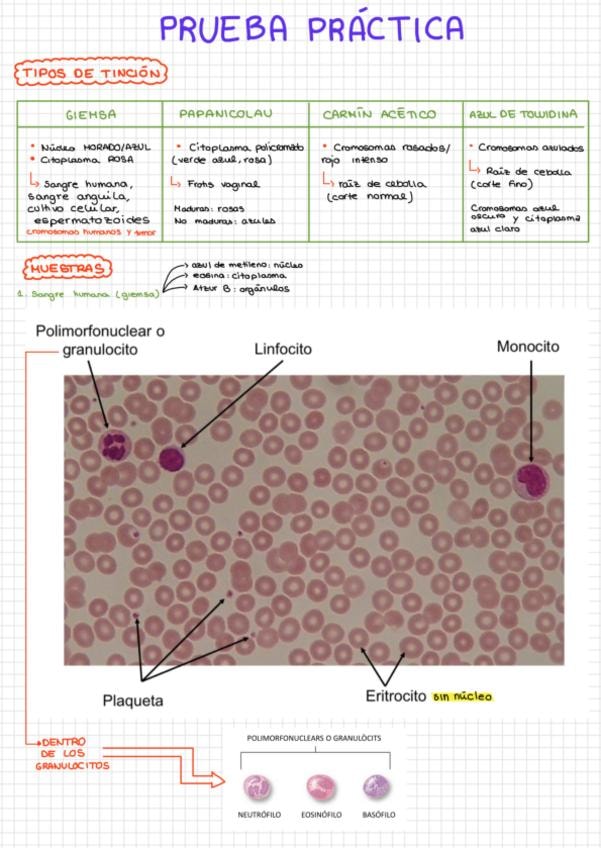

Morfología nivel celular
He publicado nuevos apuntes de 1º Morfología nivel celular: Tema-1-y-2-EPITELIO-DE-REVESTIMIENTO.pdf
He publicado nuevos practicas de 1º Morfología nivel celular: Practicas-histologia.pdf
apuntes
-
Parcial 2
He publicado nuevos apuntes de 1º Morfología nivel celular: Parcial 2
He publicado nuevos apuntes de 1º Morfología nivel celular: EXAMEN-PRACTICO-BIOLOGIA.pdf
He publicado nuevos practicas de 1º Morfología nivel celular: Libreta-Practicas.pdf
apuntes
-
Apuntes - Histología
He publicado nuevos apuntes de 1º Morfología nivel celular: Apuntes - Histología
apuntes
-
Apuntes Histología
He publicado nuevos apuntes de 1º Morfología nivel celular: Apuntes Histología
test
-
KAHOOTS BIOLOGÍA
Respuestas de los Kahoots de biología (evaluación continuada).
He publicado nuevos examenes de 1º Morfología nivel celular: EXAMEN-HISTOLOGIA-2025.pdf
Cuaderno prácticas morfología celular parte biología
He publicado nuevos apuntes de 1º Morfología nivel celular: KAHOOT-TEMA-8: CELULAS MADRE pdf.pdf.pdf
He publicado nuevos apuntes de 1º Morfología nivel celular: KAHOOT-TEMA-7: MITOSIS pdf.pdf
apuntes
-
Kahoots - evalucación continuada
He publicado nuevos apuntes de 1º Morfología nivel celular: Kahoots - evalucación continuada
He publicado nuevos apuntes de 1º Morfología nivel celular: Resumen-biologia-primer-parcial-completo.pdf
He publicado nuevos practicas de 1º Morfología nivel celular: Resumen-practicas-biologia.pdf
He publicado nuevos practicas de 1º Morfología nivel celular: Cuadernillo-de-practicas.pdf
He publicado nuevos apuntes de 1º Morfología nivel celular: Practicas-biologia.pdf
apuntes
-
Biología
He publicado nuevos apuntes de 1º Morfología nivel celular: Biología
He publicado nuevos practicas de 1º Morfología nivel celular: Morfologia-celular-imagenes-practicas.pdf
apuntes
-
TEMAS BIOLOGÍA
He publicado nuevos apuntes de 1º Morfología nivel celular: TEMAS BIOLOGÍA
He publicado nuevos apuntes de 1º Morfología nivel celular: CUADERNO-PRACTICAS-BIOLOGIA.pdf
He publicado nuevos apuntes de 1º Morfología nivel celular: TEMARIO-COMPLETO-HISTOLOGIA.pdf
He publicado nuevos apuntes de 1º Morfología nivel celular: histologia-en-tablas.pdf
He publicado nuevos apuntes de 1º Morfología nivel celular: Resumen-teoria-practicas-histologia.pdf
He publicado nuevos apuntes de 1º Morfología nivel celular: Libreta-Practicas-Histologia.pdf
He publicado nuevos apuntes de 1º Morfología nivel celular: Apuntes-Histologia.pdf
He publicado nuevos test de 1º Morfología nivel celular: Histologia.-Test-2.-Temas-5-9.pdf
apuntes
-
Histologia
He publicado nuevos apuntes de 1º Morfología nivel celular: Histologia
He publicado nuevos practicas de 1º Morfología nivel celular: Libreta-de-Practicas.pdf
He publicado nuevos apuntes de 1º Morfología nivel celular: GENOMA-HUMANO-tema-10-bio.pdf
He publicado nuevos apuntes de 1º Morfología nivel celular: EL-NUCLEO-CELULAR-tema-6.pdf
apuntes
-
Apuntes por temas
He publicado nuevos apuntes de 1º Morfología nivel celular: Apuntes por temas
He publicado nuevos practicas de 1º Morfología nivel celular: cuaderno-practicas-histologia-parcial-2.pdf
He publicado nuevos practicas de 1º Morfología nivel celular: Practicas-biologia-resumen.pdf
He publicado nuevos apuntes de 1º Morfología nivel celular: Apuntes-BIOLOGIA-completos.pdf
apuntes
-
apuntes histología
He publicado nuevos apuntes de 1º Morfología nivel celular: apuntes histología
apuntes
-
apuntes biología
He publicado nuevos apuntes de 1º Morfología nivel celular: apuntes biología
He publicado nuevos apuntes de 1º Morfología nivel celular: 1er-test-histologia.pdf
He publicado nuevos apuntes de 1º Morfología nivel celular: Test-histologia-2a-semana.pdf
He publicado nuevos apuntes de 1º Morfología nivel celular: capturas-histo1.pdf
He publicado nuevos apuntes de 1º Morfología nivel celular: Tema-1-Histologia.pdf
He publicado nuevos apuntes de 1º Morfología nivel celular: HISTOLOGIA-APUNTES-COMPLETOS.pdf
He publicado nuevos examenes de 1º Morfología nivel celular: EXAMEN-HISTO-23-24.pdf
He publicado nuevos apuntes de 1º Morfología nivel celular: T16-Aparato-circulatorio.pdf